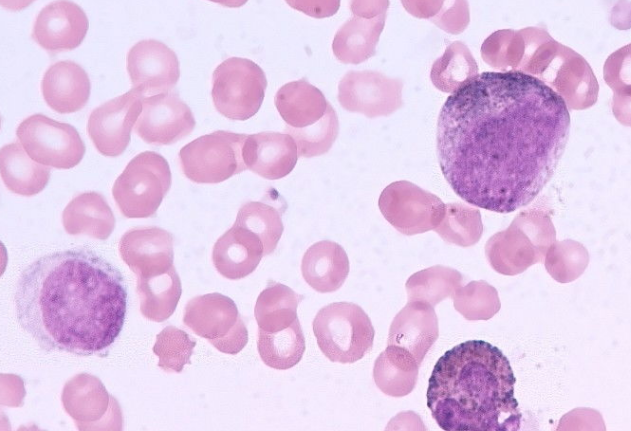

急性髓细胞白血病的强化和非强化治疗取得了哪些进展?无论是强化或非强化治疗,单纯化疗已不再是研究的重点,化疗联合靶向药物是当前的研究方向。在强化治疗方面,BCL-2抑制剂静脉曲张联合强化治疗在急性髓系白血病患者中显示出相当大的疗效,一线治疗的ORR达到90%以上,二线治疗的ORR达到60% ~ 70%,效果非常好。
然而,应该指出的是,BCL-2抑制剂的副作用包括白细胞减少/粒细胞缺乏等。因此,在与强化治疗相结合时,应更加重视剂量和副作用,需要进一步研究和探索。在非强化治疗方面,此次ASH会议的研究表明,含IDH1抑制剂的去甲基化药物可使急性髓系白血病患者的ORR达到70%以上,其中CR可达到50%,这比单用氮杂胞苷、地西他滨或IDH1抑制剂的治疗有显著改善。
此外,在急性髓系白血病的维持治疗方面,ASH会议上的研究表明,口服氮胞苷维持治疗可以显著延长老年急性髓系白血病患者的生存期。因此,对于老年急性髓系白血病患者,阿扎胞苷在诱导和巩固治疗后可用于维持治疗,有助于提高患者的生存率。对于新诊断的急性髓系白血病患者,等待1周不会影响患者的生存结果。为了在诱导治疗阶段根据遗传信息选择有效的治疗靶向药物,有必要进一步提高遗传检查的效率。